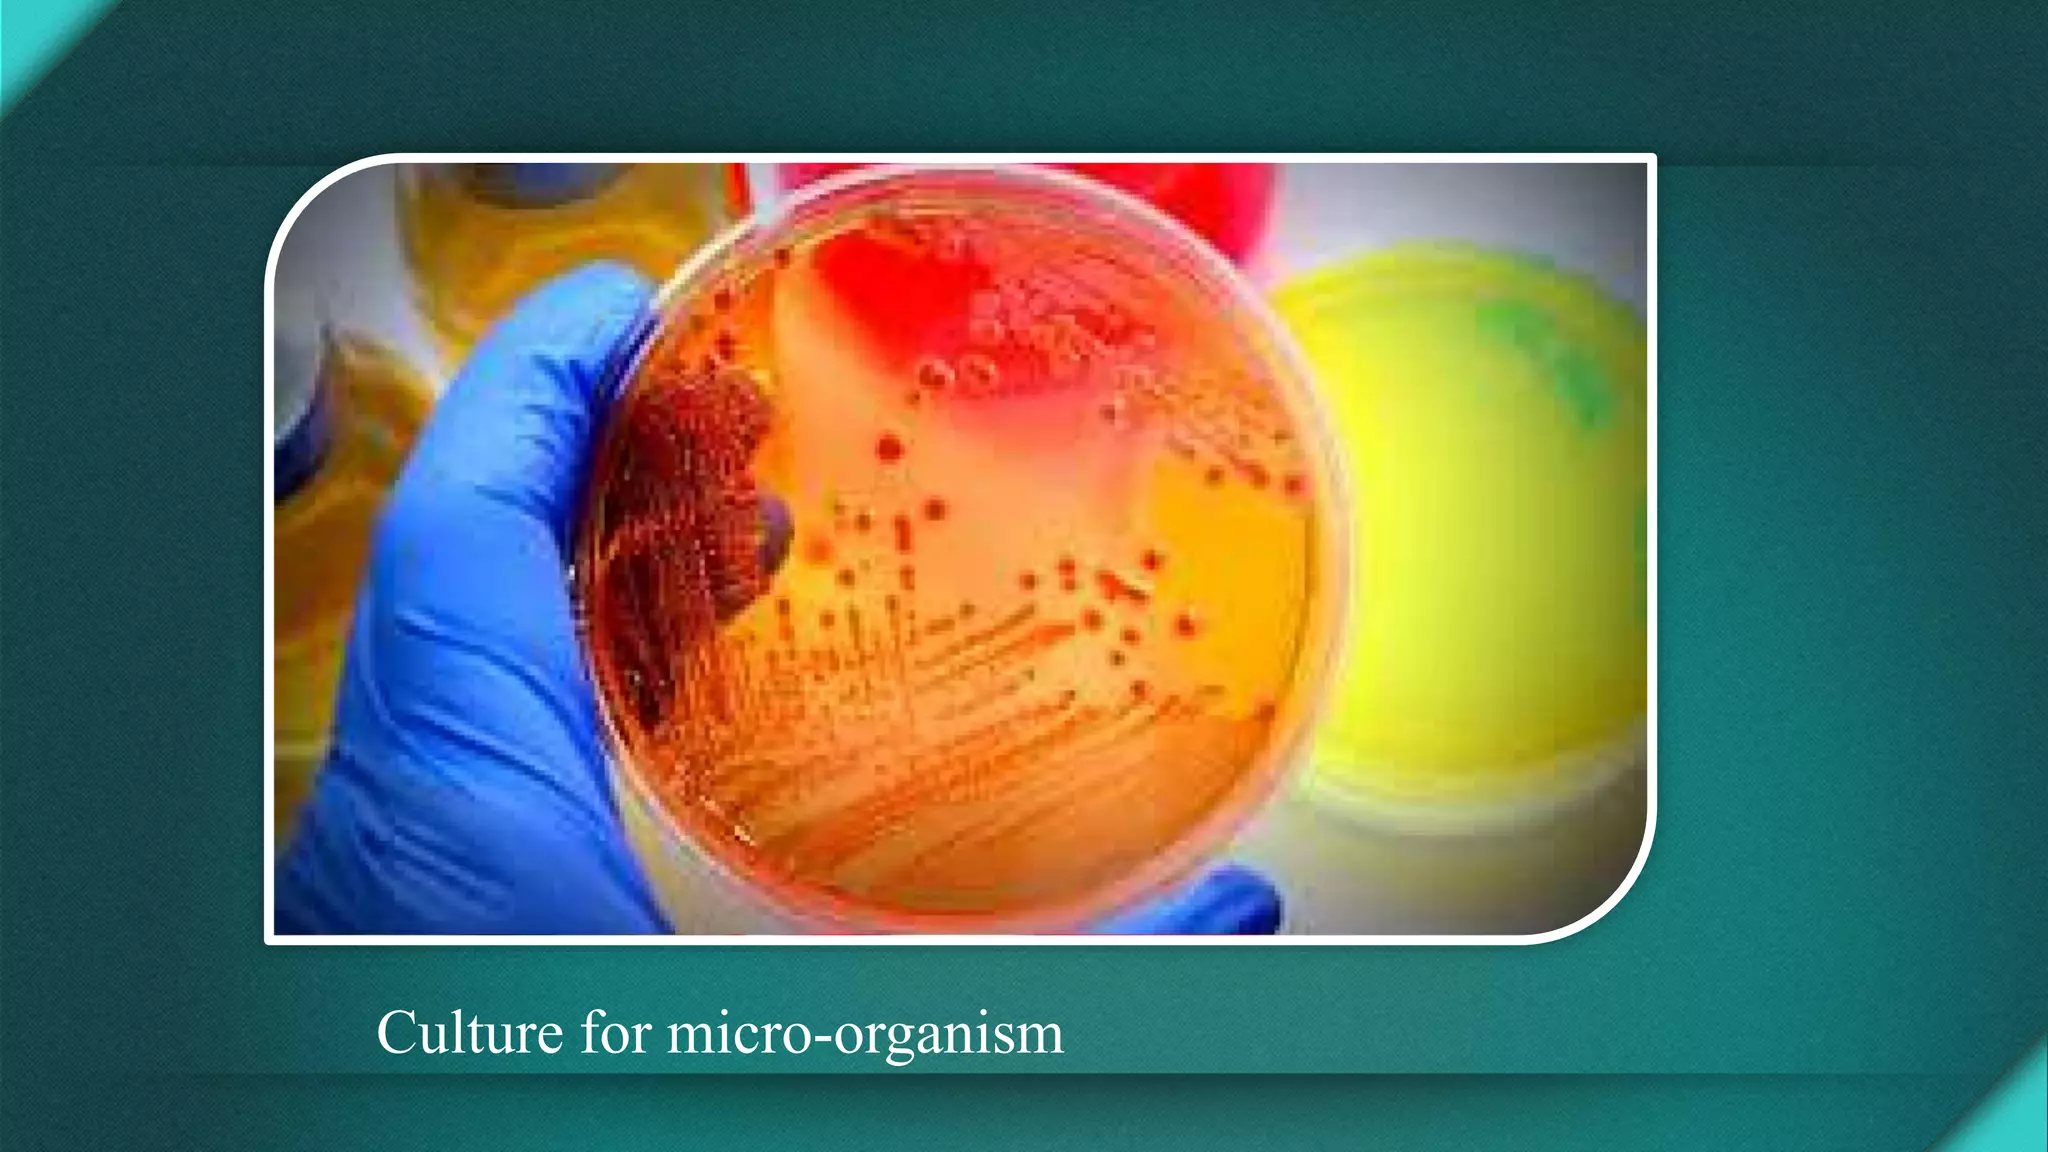
Culture for micro-organism

This document discusses principles of antimicrobial therapy. It begins by classifying antimicrobials based on their source, mechanism of action, and spectrum. Narrow, extended, and broad spectrum antimicrobials are defined. The document emphasizes selecting the appropriate antimicrobial based on the infecting organism, patient factors, and pharmacokinetic properties. It stresses starting empiric therapy and then narrowing based on culture results. Monitoring treatment response and adjusting for toxicity or resistance is also highlighted. The goal of antimicrobial use is effective treatment of infection while limiting emergence of resistance.